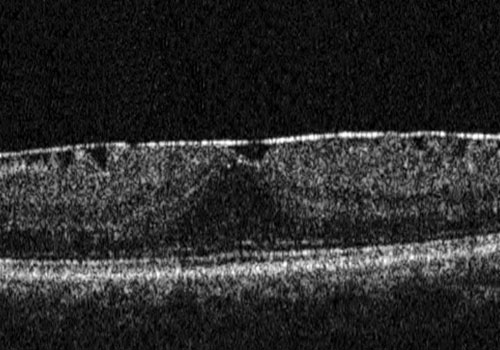

info@poliambulatoriodellemuse.it
071 206975
info@poliambulatoriodellemuse.it
071 206975
Membrana epiretinica
Home / Info Pazienti / Oftalmologia / Patologie della retina / MEMBRANA EPIRETINICA
È una membrana fibrocellulare che si forma sulla superficie retinica interna per la proliferazione di cellule gliali migrate attraverso rotture della membrana limitante interna. Il risultato è rappresentato da un "raggrinzimento" della porzione centrale della retina, da cui deriva una distorsione delle immagini e un calo visivo, che può peggiorare nel tempo.
-
+ Approfondisci
Eziologia
Nella maggior parte dei casi la causa è idopatica, cioè senza causa nota. In altri casi può essere secondaria ad alcune patologie come processi infiammatori oculari (uveiti), emorragie vitreali, rotture retiniche, laser trattamento periferico, traumi e interventi chirurgici.
Sintomatologia
Può essere variabile in base all'entità della membrana epiretinica stessa. Nei casi più lievi (maculopatia "a cellophane") può essere asintomatica e si raccomanda solo il controllo nel tempo per valutare eventuali modificazioni.
Nei casi più gravi la membrana tende a contrarsi e a stirare la superficie retinica. Il paziente inizia a lamentarsi di una visione distorta (metamorfopsia) e di un variabile grado di diminuzione dell'acuità visiva.
Nel caso in cui il paziente veda le righe ondulate, è importante rivolgersi prontamente al proprio oculista di fiducia.
Trattamento
Intervenire con la giusta tempistica riduce la perdita visiva e migliora il recupero visivo funzionale.
L’intervento di elezione è la vitrectomia con sistemi mini invasivi (25 o 27 gauge) e prevede il peeling della membraa epiretinica e della limitante interna.